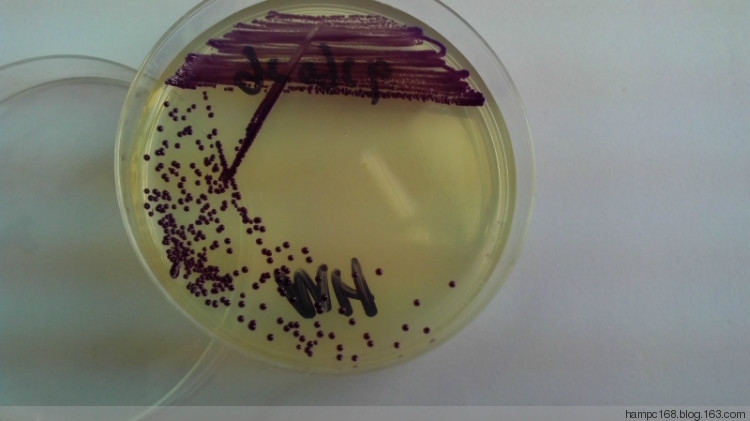
MHA 24h菌落.jpg MHA 24h菌落.jpg

本帖最后由 乔-乔 于 2013-11-30 06:49 编辑
紫色色杆菌寄居在土壤,水中,是蒹性厌氧的G[sup]-[/sup]B。由皮肤破损感染引起的败血症死亡率高,属条件致病菌,多数病例发生在热带和亚 热 带,可引起人类的泌尿系感染,局部脓肿,腹泻和多种器官感染。感染途径是水或土壤污染伤口等所致,污染食物引起腹泻。
紫色色杆菌有些菌株在血平板上菌落有紫色色素,部分菌落则无。氧化酶阳性无色素菌株易误认为气单胞菌属(但麦芽糖和
甘露醇阴性)或弧菌科细菌;氧化酶阴性菌株易误认为肠杆菌科细菌。紫色色杆菌对氨基糖甙类、氯霉素和四环素敏感,但对青霉素和头孢菌素类耐药。
特别提示:
紫色色杆菌,典型特征是菌落呈紫黑色色素,此菌寄居于土壤、水中,由皮肤破损所致感染,应考虑与提供的临床资料相符。所以临床微生物鉴定既要根据生物学特性、生化反应、标本来源、临床资料、菌株共性等,又要抓住其个性和典型特性,进行全面分析,这样才有可能得出正确结果。

BAC 24h菌落

MAC 24h菌落

产色株及不产色株
MHA 24h菌落

MHA 36h菌落

|
 /1
/1 